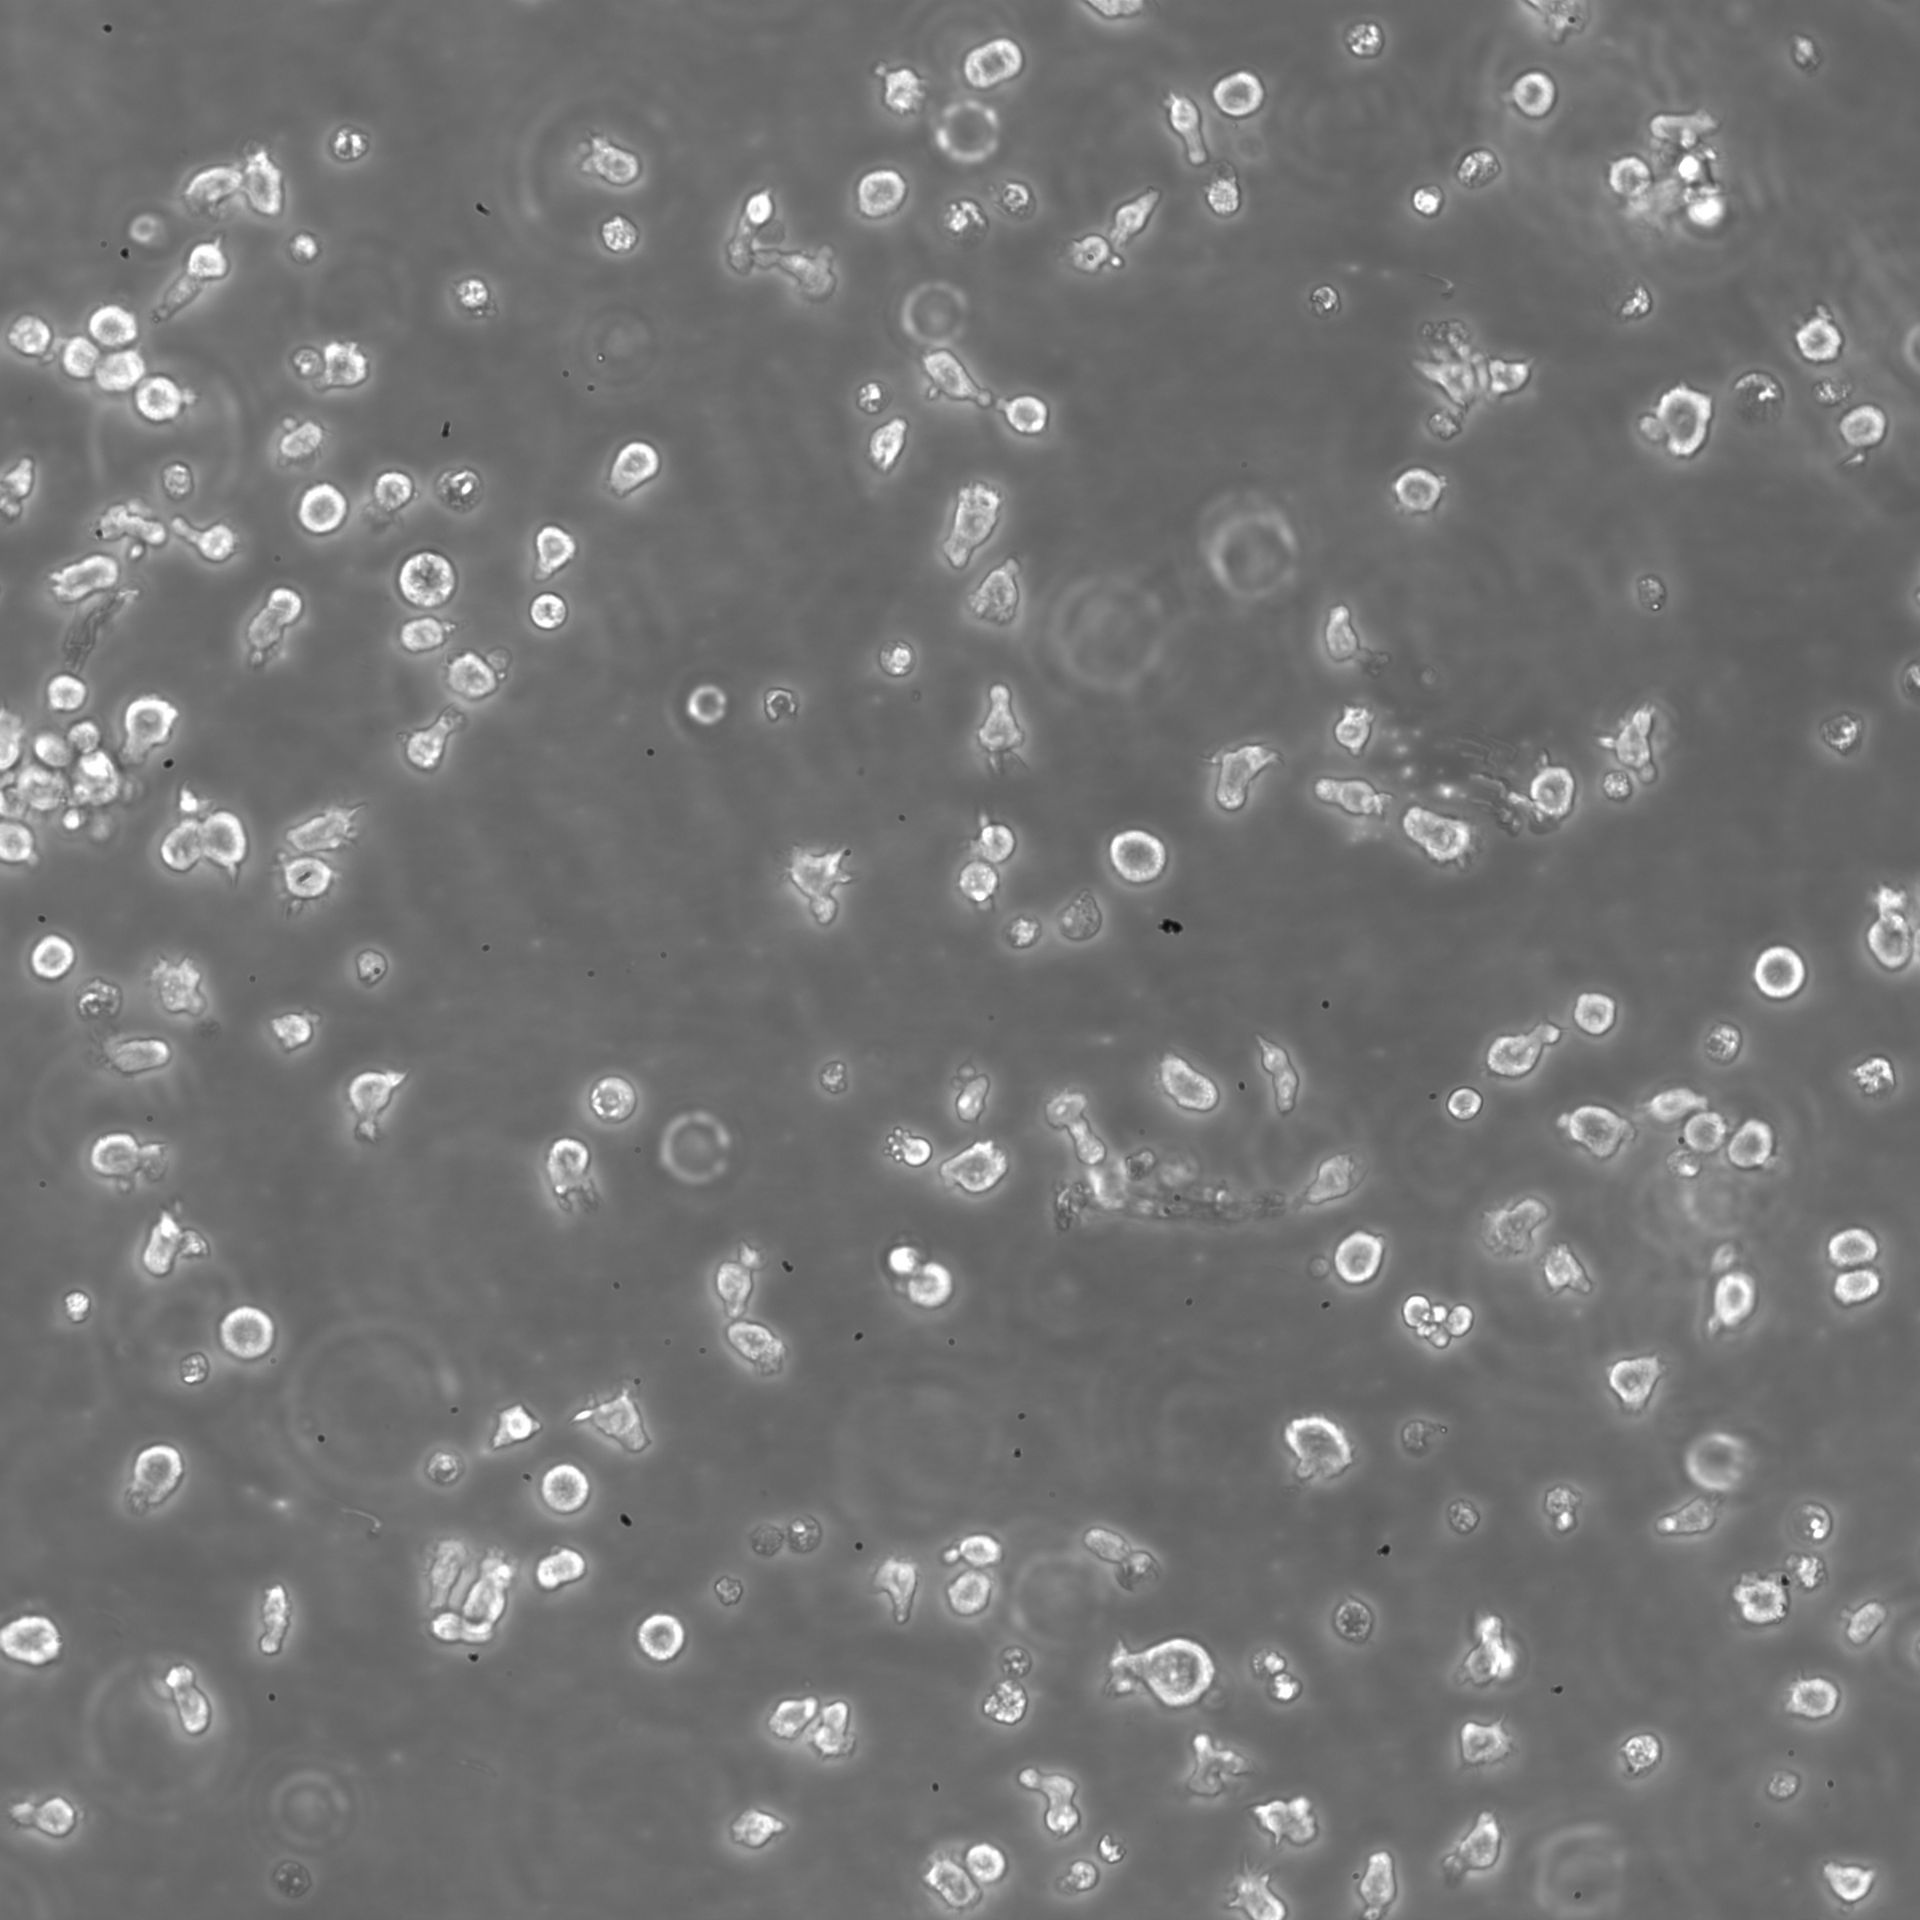

IM-9
基本信息
B26699
IM 9; IM9; GM04680
IM-9
活细胞(默认)或干冰寄送
培养方法
90%RPMI-1640+10% FBS
Temperature: 37°C ; Carbon dioxide (CO₂), 5%
贴壁细胞
90% FBS(优质) + 10% DMSO;存于液氮中
详细说明
质保:必欧承诺对细胞质量永久质保!永久售后!
承诺:本库细胞均经过支原体检测(PCR assay)、内毒素检测等质检。相关检测报告及STR鉴定报告将随细胞发给您。我们只提供“低代数”细胞并且严格遵循《Culture of Animal Cells,7th Edition》规定,力求做好每一个细节!
承诺:本库细胞均经过支原体检测(PCR assay)、内毒素检测等质检。相关检测报告及STR鉴定报告将随细胞发给您。我们只提供“低代数”细胞并且严格遵循《Culture of Animal Cells,7th Edition》规定,力求做好每一个细节!